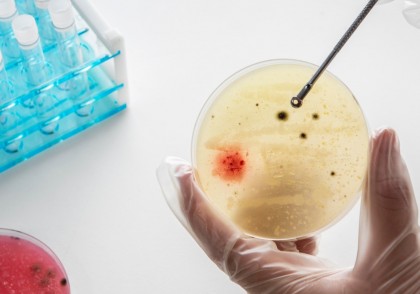
Tulpinile pandemice de holeră din America Latină posedă sisteme complexe de apărare anti-fagică

Tulpinile pandemice de holeră din America Latină posedă sisteme complexe de apărare anti-fagică
Un nou studiu publicat pe 20 mai 2025 în revista Nature Microbiology, realizat de cercetători de la EPFL – Global Health Institute, oferă o explicație moleculară pentru dimensiunea și severitatea epidemiei de holeră din America Latină din anii ’90. Cercetarea arată că tulpinile de Vibrio cholerae din linia West African–South American (WASA) au acumulat sisteme avansate de apărare anti-fagică, ceea ce le-a permis să evite infecția virală și să se răspândească rapid în populație.
Context
Vibrio cholerae, agentul cauzator al holerei, este cunoscut pentru capacitatea sa de a provoca epidemii devastatoare. Totuși, în mediul natural, aceste bacterii se confruntă cu un dușman invizibil: bacteriofagii (fagii) – virusuri care infectează și distrug bacteriile. În regiunile endemice, anumiți fagi, precum ICP1 în Bangladesh, pot limita răspândirea V. cholerae, acționând ca un control natural al bolii.
Epidemia din Peru și America Latină din 1991–1994, care a afectat peste 1 milion de persoane, a fost cauzată de tulpini WASA. Mecanismul prin care aceste tulpini au evitat controlul fagic nu era clar până în prezent.
Despre studiul actual
Echipa condusă de prof. Melanie Blokesch a analizat tulpini peruviene din perioada epidemiei și le-a comparat cu tulpini ale pandemiei a 7-a (7PET), testând rezistența acestora la fagii ICP1 și alți fagi vibriopatici.
Metodologie
-
Au fost utilizate metode genetice pentru a șterge regiuni specifice din genom și pentru a transfera aceste regiuni în alte tulpini bacteriene, testând astfel funcționalitatea acestora.
-
Rezistența la fagii ICP1 și alți vibriofagi a fost evaluată în laborator.
-
A fost analizată prezența elementelor mobile genetice, cum ar fi profagul WASA-1 și insula genomică VSP-II.
Rezultate
Studiul a identificat trei sisteme distincte de apărare în tulpinile WASA, fiecare cu funcții specializate împotriva fagilor:
-
WonAB – induce un mecanism de infecție abortivă, în care bacteria infectată se auto-sacrifică înainte ca virusul să se poată replica. Acest sistem oprește răspândirea fagiului chiar dacă bacteria moare.
-
GrwAB – detectează ADN-ul modificat chimic al anumitor fagi, o strategie prin care virusurile își maschează genomul pentru a evita sistemele bacteriene clasice.
-
VcSduA – protejează împotriva altor familii de vibriophage, oferind o protecție extinsă și redundantă.
Aceste mecanisme de apărare conferă tulpinilor WASA imunitate la fagi dominanți, inclusiv ICP1, ceea ce nu se observă la alte tulpini ale pandemiei.
Implicații
Studiul oferă o explicație moleculară clară pentru succesul tulpinilor WASA în declanșarea unei epidemii majore. În lipsa presiunii exercitate de fagi, aceste tulpini au avut un avantaj ecologic semnificativ, ceea ce le-a permis să infecteze mai mulți oameni într-un timp scurt.
Mai mult, aceste descoperiri sunt relevante și pentru terapiile fagice, o alternativă promițătoare la antibiotice. Dacă bacteriile își pot adapta sistemele imunitare pentru a evita fagi terapeutici, este crucial să înțelegem interacțiunile dintre bacterii și fagi în contextul bolilor infecțioase.
Concluzii
Acest studiu evidențiază complexitatea interacțiunilor microbiene și arată că imunitatea bacteriană la fagi poate influența direct epidemiologia bolilor precum holera. În viitor, monitorizarea acestor sisteme genetice de apărare ar putea ajuta la anticiparea severității unei epidemii și la dezvoltarea de tratamente adaptate.
Image by freepik
Copyright ROmedic: Articolul se află sub protecția drepturilor de autor. Reproducerea, chiar și parțială, este interzisă!
- Noi descoperi științifice pot ajuta la dezvoltarea tratamentului inflamației cronice
- Un nanomaterial eficient în prevenirea infecțiilor asociate implanturilor
- Virusurile gripale aviare și rezistența acestora la febră, sau cum o singură genă poate transforma o infecție severă într-o pandemie
- Blocarea unei proteine cheie întărește imunitatea împotriva infecțiilor cu Aspergillus fumigatus
intră pe forum